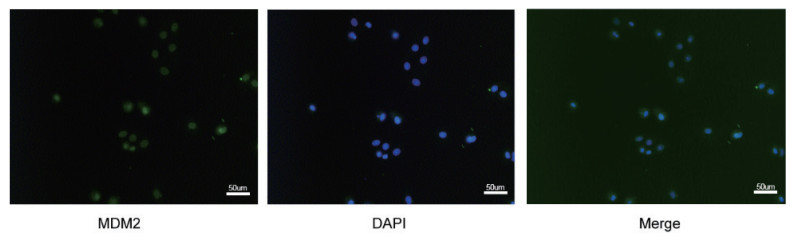

2. 贵州医科大学附属医院重症医学科,贵阳 550004;
3. 遵义市中医院重症医学科,遵义 563000
2. Department of Critical Care Medicine, Affiliated Hospital of Guizhou Medical University, Guiyang 550004, China;
3. Department of Critical Care Medicine, Zunyi Hospital of Traditional Chinese Medicine, Zunyi 563000, China
机械通气可显著改善危重症患者的预后,但长期吸入高氧体积分数后会诱发高氧性急性肺损伤(HALI),导致肺组织坏死和纤维化进一步发展,最终会导致成人ARDS和新生儿支气管肺发育不良的结果[1]。ROS介导的Ⅱ型肺泡上皮细胞凋亡是HALI发病的主要机制之一。抑制AECII凋亡可有效减轻小鼠HALI程度[2-3]。因此,研究其信号通路,明确其分子机制,对于预防和靶向治疗HALI具有重要意义。
p53是一种重要的肿瘤抑制基因,能促进细胞凋亡,抑制细胞增殖。ROS可激活p53介导的凋亡通路 [4]。此外,p53蛋白可直接刺激线粒体释放ROS,诱导细胞凋亡,下调p53的表达可减少ROS的产生和细胞凋亡[5]。p53蛋白可转位至线粒体表面并与Bcl-2家族蛋白直接结合促进细胞凋亡,p53还可以促进线粒体外膜通透性的改变,导致细胞色素C、Smac/diablo IAP结合线粒体蛋白等细胞间促凋亡因子从线粒体膜间隙释放到细胞质和细胞核,从而激活下游蛋白caspase家族,启动凋亡过程[6]。基于上述研究基础,对HALI小鼠转录组测序结果进行KEGG富集,发现p53信号通路与HALI密切相关。
鼠双微立体基因2 (MDM2)是Akt信号通路下游的一种E3泛素连接酶,可与p53蛋白结合,其结构包括p53结合域和锌指域[7-8]。正常情况下,MDM2与p53相互调节形成负反馈回路,p53蛋白调节MDM2基因的转录,p53蛋白表达增加导致MDM2基因转录增强,合成的MDM2蛋白又与p53结合,导致p53泛素化降解[9]。PI3K/AKT信号通路的主要抗凋亡机制之一是Akt促进MDM2向细胞核转移,降解p53,从而抑制凋亡信号转导通路 [10-11]。研究发现发现抑制A549细胞中MDM2蛋白表达可上调p53蛋白,促进细胞凋亡[12]。MDM2是否参与HALI细胞凋亡的调控尚不清楚。通过对MDM2与p53之间的调控关系的研究可能对HALI的潜在机制提供了更深入的了解。
1 材料与方法 1.1 实验动物雄性C57BL/6J小鼠(20~25 g, 6~8周龄)购自长沙天琴生物科技有限公司,动物许可证号: SCXK(湘2019-0004)。本研究经遵义医学院实验动物与使用伦理委员会批准,批准号: 〔2023〕1-083)。
1.2 HALI动物模型将小鼠置于密闭的塑料舱内(中国长沙长金科技公司)暴露于高氧72 h,小鼠的氧体积分数约为5.0 L/min,以维持氧体积分数大于90%)[13]。
1.3 转录组分析高氧造模后采用戊巴比妥麻醉,安乐处死小鼠,取肺组织进行液氮冷冻。采用华大T7测序平台进行文库的双末端测序,将测序得到的数据进行基因的差异表达、KEGG富集分析。
1.4 细胞模型0.5 mmol/L H2O2干预MLE-12细胞24 h模拟氧化损伤模型。
1.5 腺病毒载体的构建共设计了3条靶向小鼠MDM2序列的短发夹RNA(表 1)。另外还设计了一个带有scrambled序列的阴性对照(NC) shRNA。采用pGCSIL-GFP载体(汉生物生物技术有限公司)包装含有MDM2 shRNA和NC shRNA的重组腺病毒(LV)。LV-MDM2 shRNA1、LV-MDM2 shRNA2、LV-MDM2 shRNA3和LV-NC的最终滴度均为3 × 108 TU/mL。由于LV-MDM2 shRNA3的敲低效果最好,因此选择其进行后续实验。将MDM2序列(表 1)直接合成到pHBLV-CMV-MCS-3flag-EF1-puro载体(汉生物生物技术有限公司)。
| shRNA name | Strand | Sequence |
| NC shRNA | Top strand | GATCCGTTCTCCGAACGTGTCACGTAATTCAAGAGATTACGTGACACGTTCGGAGAATTTTTTC |
| NC shRNA | Bottom strand | AATTGAAAAAATTCTCCGAACGTGTCACGTAATCTCTTGAATTACGTGACACGTTCGGAGAACG |
| shRNA1 | Top strand | GATCCGGACAGTATATTATGACTAATTCAAGAGATTAGTCATAATATACTGTCTTTTTTC |
| shRNA1 | Bottom strand | AATTGAAAAAAGACAGTATATTATGACTAATCTCTTGAATTAGTCATAATATACTGTCCG |
| shRNA2 | Top strand | GATCCGCTTAGTGGTTGTAAGTCAATTCAAGAGATTGACTTACAACCACTAAGTTTTTTC |
| shRNA2 | Bottom strand | AATTGAAAAAACTTAGTGGTTGTAAGTCAATCTCTTGAATTGACTTACAACCACTAAGCG |
| shRNA3 | Top strand | GATCCGGGATTCAGTTTCTGATCAATTCAAGAGATTGATCAGAAACTGAATCCTTTTTTC |
| shRNA3 | Bottom strand | AATTGAAAAAAGGATTCAGTTTCTGATCAATCTCTTGAATTGATCAGAAACTGAATCCCG |
使用细胞计数试剂盒-8 (CCK-8)检测细胞活力(碧云天生物技术研究所)。MLE-12细胞经H2O2处理24 h后,按照说明书,在450 nm波长下检测混合物的OD值。
1.7 流式细胞仪检测细胞凋亡和坏死情况Annexin V-FITC/PI染色后观察MLE-12细胞凋亡和坏死情况[14]。按照制造商的说明,使用Annexin V-FITC和PI染色试剂盒(BD Biosciences)估计MLE-12细胞表面磷脂酰丝氨酸的水平。采用FACSC alibur流式细胞仪(BD Biosciences)检测MLE-12细胞凋亡率和坏死发生情况。
1.8 免疫荧光检测MDM2MLE-12细胞用4%多聚甲醛固定,用10%山羊血清封闭,然后用抗mdm2抗体孵育。MLE-12细胞随后与FITC标记的二抗孵育。洗涤后用DAPI复染细胞核,荧光显微镜拍摄免疫荧光图像。
1.9 免疫共沉淀以50 mmol/L Tris·HCl (pH 9.0)、10.0 mmol/L EDTA、1.0%脱氧胆酸钠和蛋白酶/磷酸酶抑制剂在37˚C条件下提取MLE-12细胞组分30 min。在上述提取液中加入等体积的稀释缓冲液。在14 000 g离心后,收集上清液,并与抗p53抗体在4˚C孵育过夜。将蛋白A/G琼脂糖珠与免疫复合物孵育4 h。洗涤3次后,将免疫沉淀重悬在十二烷基硫酸钠样品缓冲液中,煮沸5 min,然后进行western blotting。免疫复合物用蛋白A/g-琼脂糖珠进行沉淀。
1.10 Western blotting用10% SDS-PAGE凝胶电泳分离蛋白,将该蛋白转移到PVDF膜上,用5%脱脂牛奶在室温下封闭2 h,然后与相应一抗4˚C孵育过夜。然后用PBS-Tween 20 (PBST)洗涤3次,每次10 min,二抗在室温下孵育2 h,然后用PBST洗涤3次,每次10 min。采用凝胶图像处理系统(image - pro Plus 6.0)曝光处理。
1.11 统计学方法使用IBM SPSS 26.0统计软件进行数据分析。符合正态分布的计量资料以均数±标准差(x±s)表示,多组间比较采用单因素方差分析,以P<0.05为差异有统计学意义。
2 结果 2.1 转录组结果对正常小鼠和高氧72 h小鼠肺组织进行转录组测序,筛选差异表达基因进行聚类分析和KEGG富集分析,从而确定受显著影响的信号转导通路。结果显示,p53信号通路与HALI密切相关(图 1)。(A)差异基因聚类分析结果; (B)火山差异基因图谱; (C)差异基因的KEGG富集分析结果。

|
| 图 1 各组肺组织RNA-Seq结果 Fig 1 RNA-Seq Results of Lung Tissue in Each Group |
|
|
采用western blotting检测对照组和H2O2组中p53和MDM2的蛋白表达。与正常组相比,H2O2组p53蛋白表达水平升高、MDM2蛋白表达水平降低(P<0.05) (图 2)。

|
| 与Control组比较,aP<0.05 图 2 各组MLE-12细胞p53和MDM2的蛋白表达 Fig 2 Protein expression of p53 and MDM2 in LE-12 cells of each group |
|
|
FCM检测携带GFP标签的腺病毒感染MLE-12的感染效率。结果表明,感染效率为93.7%±0.25%。感染效率高于90%,表明腺病毒感染模型建立成功,可用于后续实验(图 3A);MDM2 shRNA1组、MDM2 shRNA2组和MDM2 shRNA3组的MDM2蛋白表达较空载体组降低,表明3个干扰组的MDM2基因沉默成功,其中MDM2 shRNA3沉默效果最佳(图 3B、C)。

|
| A: 用流式细胞术评价腺病毒感染效率,感染效率为93.7%。B-C: MDM2-shRNA在体外MLE-12细胞中下调MDM2表达。与Empty vector组比较,aP<0.05; 与shRNA1组比较,bP<0.05;与shRNA2组比较,cP<0.05 图 3 shRNA和MDM2过表达载体对体外MLE-12细胞MDM2表达的干预 Fig 3 shRNA and MDM2 expression vector expression of MDM2 MLE-12 cells in vitro intervention |
|
|
同时H2O2造模后24 h采用qPCR检测各组MDM2 mRNA表达水平,结果显示MDM2过表达组MDM2 mRNA表达水平较空载体组显著升高,MDM2沉默组MDM2 mRNA表达水平较空载体组显著降低(P<0.05),表明MDM2过表达和沉默模型构建成功,与MDM2过表达组比较,MDM2过表达+ H2O2组的MDM2的mRNA水平显著降低(P<0.05);与MDM2沉默组相比,MDM2沉默+ H2O2组的MDM2 mRNA表达水平显著降低(P<0.05),说明H2O2可以抑制MDM2 mRNA的表达(图 4)。

|
| 与Empty vector组比较, aP<0.05;与MDM2 overexpressed组比较, bP<0.05;与MDM2-shRNA组比较, cP<0.05;与MDM2 overexpressed+H2O2组比较, dP<0.05 图 4 qPCR检测各组MDM2 mRNA表达水平 Fig 4 The mRNA expression level of MDM2 detected by qPCR in each group |
|
|
CCK-8检测24 h各组细胞增殖情况,结果显示空载体组MLE-12增殖能力与健康对照组比较差异无统计学意义(P>0.05),说明LV不影响MLE-12增殖,H2O2组MLE-12增殖速度减慢(P<0.05)。与空载体组比较,MDM2过表达后增殖加快,MDM2沉默后增殖减慢(P<0.05),表明MDM2对MLE-12的增殖有促进作用。与H2O2组相比,MDM2过表达+ H2O2组MLE-12增殖加快,而MDM2沉默+ H2O2组MLE-12增殖减慢(P<0.05),说明MDM2可以促进H2O2损伤时MLE-12增殖(图 5)。

|
| 与Control组比较, aP<0.05;与H2O2组比较, bP<0.05;与Empty vector组比较, cP<0.05;与MDM2 overexpressed组比较, dP<0.05;与MDM2-shRNA组比较, eP<0.05;与MDM2 overexpressed+H2O2组比较, fP<0.05 图 5 qPCR检测各组MDM2 mRNA表达水平 Fig 5 The mRNA expression level of MDM2 etected by qPCR in each group |
|
|
流式细胞术检测MLE-12细胞总凋亡率及坏死情况,各组细胞总凋亡率及坏死均随时间延长而增加(P<0.05)。与健康对照组比较,H2O2组细胞凋亡坏死升高(P<0.05);与MDM2过表达组相比,MDM2过表达+ H2O2组细胞凋亡坏死升高(P<0.05);在MDM2沉默+ H2O2组中,与MDM2沉默组相比,细胞凋亡坏死升高(P<0.05),说明H2O2可以促进MLE-12细胞凋亡。与H2O2组相比,MDM2过表达+ H2O2组的细胞凋亡坏死降低(P<0.05),而MDM2沉默+ H2O2组AEC Ⅱ细胞的凋亡坏死升高(P<0.05),说明MDM2在H2O2诱导的MLE-12细胞损伤中发挥抗凋亡作用(图 6)。

|
| 与Control组比较, aP<0.05;与H2O2组比较, bP<0.05;与MDM2 overexpressed组比较, cP<0.05,;与MDM2-shRNA组比较, dP<0.05;与MDM2 overexpressed+H2O2组比较, eP<0.05 图 6 流式细胞术检测MLE-12细胞总凋亡率及坏死情况 Fig 6 The total apoptosis rate and necrosis of MLE-12 cells were determined by flow cytometry |
|
|
免疫荧光数据显示MDM2蛋白表达存在于细胞核内,表明内源性MDM2在细胞核内表达(图 7)。
|
| 图 7 MDM2在细胞核内表达情况 Fig 7 Expression of MDM2 in the nucleus |
|
|
在MLE-12中转染p53抗体检测MDM2与p53的物理结合,Co-IP的结果显示MDM2蛋白可与p53蛋白结合(图 8)。

|
| 图 8 MDM2与p53的蛋白质免疫共沉淀结果 Fig 8 Results of co-immunoprecipitation between MDM2 and p53 |
|
|
Western blot检测MDM2、p53、Bcl-2、Bax在H2O2建模后的蛋白表达水平。研究结果表明,MDM2过表达能够上调MDM2和BCl-2蛋白表达水平,而p53、Bax蛋白表达水平则有所下降(P < 0.05)。MDM2沉默后MDM2、Bcl-2蛋白表达水平下降,p53、Bax蛋白表达水平升高(P<0.05) (图 9)。这些数据表明MDM2具有抗凋亡作用。

|
| 与vector组比较, aP<0.05;与MDM2 overexpressed组比较, bP<0.05;与MDM2-shRNA组比较, cP<0.05;与vector+H2O2组比较, dP<0.05;与MDM2 overexpressed+H2O2组比较, eP<0.05 图 9 Western blot检测MDM2、p53、Bcl-2、Bax在H2O2建模后的蛋白表达水平 Fig 9 The protein expression levels of MDM2, p53, Bcl-2 and Bax after H2O2 modeling were detected by Western blo |
|
|
本研究中发现MDM2在H2O2诱导的MLE-12中表达较低,MDM2在MLE-12中具有抗凋亡作用。此前,笔者用0.5 mmol/L H2O2构建了HALI体外细胞凋亡模型,并在体外验证了PI3K/Akt信号通路参与AEC II细胞凋亡。MDM2基因是一个致癌基因,作为p53的负调控因子和Akt的下游靶点[15]。分子生物学水平层面H2O2可诱导PI3K/Akt通路的激活,降低磷酸化Akt的比率,从而阻断p-Akt诱导的MDM2对p-MDM2的激活,表现为MDM2的表达降低[16],因此有理由相信抑制p53能够对机体产生有利的作用。线粒体是体内ROS的主要来源,也是受到HALI攻击的主要细胞器[17],ROS还可以促进STAT3磷酸化造成肺损伤。细胞凋亡途径有三种: 外源性、内源性和内质网途径。内源性途径也被称为线粒体凋亡途径。线粒体是细胞内ROS的主要来源,也是ROS的主要靶点。功能障碍的线粒体产生大量ROS,导致线粒体膜脂质过氧化,线粒体膜电位下降(Δψm),线粒体通透性转运孔开放,细胞色素c释放,促凋亡蛋白Bax、Bak上调,抗凋亡蛋白Bcl-2、Bcl- XL表达抑制,caspase-9、caspase-3激活,从而诱导细胞凋亡[18]。有报道称,抑制小鼠神经元中ROS的产生可以维持Δψm的稳定,上调Bcl-2的表达,减少神经元凋亡[19]。线粒体凋亡途径是细胞凋亡的经典途径之一。线粒体膜电位下降是早期凋亡的重要标志。当ROS过量产生时,线粒体膜的通透性增加,线粒体膜电位下降。
利益冲突 所有作者声明无利益冲突
作者贡献声明 郑杰、陈博文、刘鑫鑫、冯帮海主要负责实验操作;余琨、余虹、廖贞亮主要负责统计学分析;梅鸿,陈淼负责研究设计;覃松、傅小云论文修改
| [1] | Syed M, Das P, Pawar A, et al. Hyperoxia causes miR-34a-mediated injury via angiopoietin-1 in neonatal lungs[J]. Nat Commun, 2017, 8(1): 1173. DOI:10.1038/s41467-017-01349-y |
| [2] | Wu D, Liang ML, Dang HX, et al. Hydrogen protects against hyperoxia-induced apoptosis in type Ⅱ alveolar epithelial cells via activation of PI3K/Akt/Foxo3a signaling pathway[J]. Biochem Biophys Res Commun, 2018, 495(2): 1620-1627. DOI:10.1016/j.bbrc.2017.11.193 |
| [3] | Qin S, Chen M, Ji H, et al. MiR-21-5p regulates type Ⅱ alveolar epithelial cell apoptosis in hyperoxic acute lung injury[J]. Mol Med Rep, 2018, 17(4): 5796-5804. DOI:10.3892/mmr.2018.8560 |
| [4] | Yu GW, Luo HW, Zhang N, et al. Loss of p53 sensitizes cells to palmitic acid-induced apoptosis by reactive oxygen species accumulation[J]. Int J Mol Sci, 2019, 20(24): 6268. DOI:10.3390/ijms20246268 |
| [5] | Chen T, Deng ZY, Zhao RL, et al. SYKT alleviates doxorubicin-induced cardiotoxicity via modulating ROS-mediated p53 and MAPK signal pathways[J]. Evid Based Complement Alternat Med, 2018, 2018: 2581031. DOI:10.1155/2018/2581031 |
| [6] | Adrain C, Creagh EM, Martin SJ. Apoptosis-associated release of Smac/DIABLO from mitochondria requires active caspases and is blocked by Bcl-2[J]. EMBO J, 2001, 20(23): 6627-6636. DOI:10.1093/emboj/20.23.6627 |
| [7] | Xie XW, Wang XY, Liao WJ, et al. MYL6B, a myosin light chain, promotes MDM2-mediated p53 degradation and drives HCC development[J]. J Exp Clin Cancer Res, 2018, 37(1): 28. DOI:10.1186/s13046-018-0693-7 |
| [8] | Trino S, De Luca L, Laurenzana I, et al. P53-MDM2 pathway: evidences for A new targeted therapeutic approach in B-acute lymphoblastic leukemia[J]. Front Pharmacol, 2016, 7: 491. DOI:10.3389/fphar.2016.00491 |
| [9] | Tian H, Tackmann NR, Jin AW, et al. Inactivation of the MDM2 RING domain enhances p53 transcriptional activity in mice[J]. J Biol Chem, 2017, 292(52): 21614-21622. DOI:10.1074/jbc.RA117.000122 |
| [10] | Liu CR, Liu Z, Li M, et al. Enhancement of auranofin-induced apoptosis in MCF-7 human breast cells by selenocystine, a synergistic inhibitor of thioredoxin reductase[J]. PLoS One, 2013, 8(1): e53945. DOI:10.1371/journal.pone.0053945 |
| [11] | Wade M, Li YC, Wahl GM. MDM2, MDMX and p53 in oncogenesis and cancer therapy[J]. Nat Rev Cancer, 2013, 13(2): 83-96. DOI:10.1038/nrc3430 |
| [12] | Zhou YL, Ho WS. Combination of liquiritin, isoliquiritin and isoliquirigenin induce apoptotic cell death through upregulating p53 and p21 in the A549 non-small cell lung cancer cells[J]. Oncol Rep, 2014, 31(1): 298-304. DOI:10.3892/or.2013.2849 |
| [13] | Liu GY, Mei H, Chen M, et al. Protective effect of agmatine against hyperoxia-induced acute lung injury via regulating lncRNA gadd7[J]. Biochem Biophys Res Commun, 2019, 516(1): 68-74. DOI:10.1016/j.bbrc.2019.04.164 |
| [14] | Deng WW, Wang Y, Long XP, et al. MiR-21 reduces hydrogen peroxide-induced apoptosis in c-kit+ cardiac stem cells in vitro through PTEN/PI3K/akt signaling[J]. Oxid Med Cell Longev, 2016, 2016: 5389181. DOI:10.1155/2016/5389181 |
| [15] | Matsuda S, Nakagawa Y, Kitagishi Y, et al. Reactive oxygen species, superoxide dimutases, and PTEN-p53-AKT-MDM2 signaling loop network in mesenchymal stem/stromal cells regulation[J]. Cells, 2018, 7(5): 36. DOI:10.3390/cells7050036 |
| [16] | Jeong SJ, Pise-Masison CA, Radonovich MF, et al. Activated AKT regulates NF-kappaB activation, p53 inhibition and cell survival in HTLV-1-transformed cells[J]. Oncogene, 2005, 24(44): 6719-6728. DOI:10.1038/sj.onc.1208825 |
| [17] | Liu XY, Xu HX, Li JK, et al. Neferine protects endothelial glycocalyx via mitochondrial ROS in lipopolysaccharide-induced acute respiratory distress syndrome[J]. Front Physiol, 2018, 9: 102. DOI:10.3389/fphys.2018.00102 |
| [18] | Zhang X, Li CF, Zhang L, et al. TRAF6 restricts p53 mitochondrial translocation, apoptosis, and tumor suppression[J]. Mol Cell, 2016, 64(4): 803-814. DOI:10.1016/j.molcel.2016.10.002 |
| [19] | Xu YQ, Wang Y, Wang GY, et al. YiQiFuMai powder injection protects against ischemic stroke via inhibiting neuronal apoptosis and PKC δ/Drp1-mediated excessive mitochondrial fission[J]. Oxid Med Cell Longev, 2017, 2017: 1832093. DOI:10.1155/2017/1832093 |
 2024, Vol. 33
2024, Vol. 33




